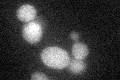
YHL016C
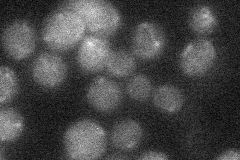
YHL016C
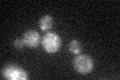
YHL016C

View description
Plasma membrane transporter for both urea and polyamines, expression is highly sensitive to nitrogen catabolite repression and induced by allophanate, the last intermediate of the allantoin degradative pathway
Localization:
Intensity:
Fold change:
Significance:
-
C’ GFP library in SD
cytosol23.77 -
N' NOP1pr-GFP in SD

cell periphery,ER45.0722 -
N' TEF2pr-mCherry in SD

ER21.0983 -
N' NATIVEpr-GFP in SD
below threshold18.1175 -
N' TEF2pr-VC and Cyto-VN in SD

below threshold22.0358 -
C’ GFP library in SD+DTT

cytosol15.660.65No -
C’ GFP library in SD+H2O2
cytosol17.70.74No -
C’ GFP library in Starvation Media

vacuole,cell peripheryN/AN/AYes -
C’ GFP library on the background of Pup2-DaMP

cytosol -
C’ GFP library on the background of CCT mutant

cytosol16.33470.687121Yes
